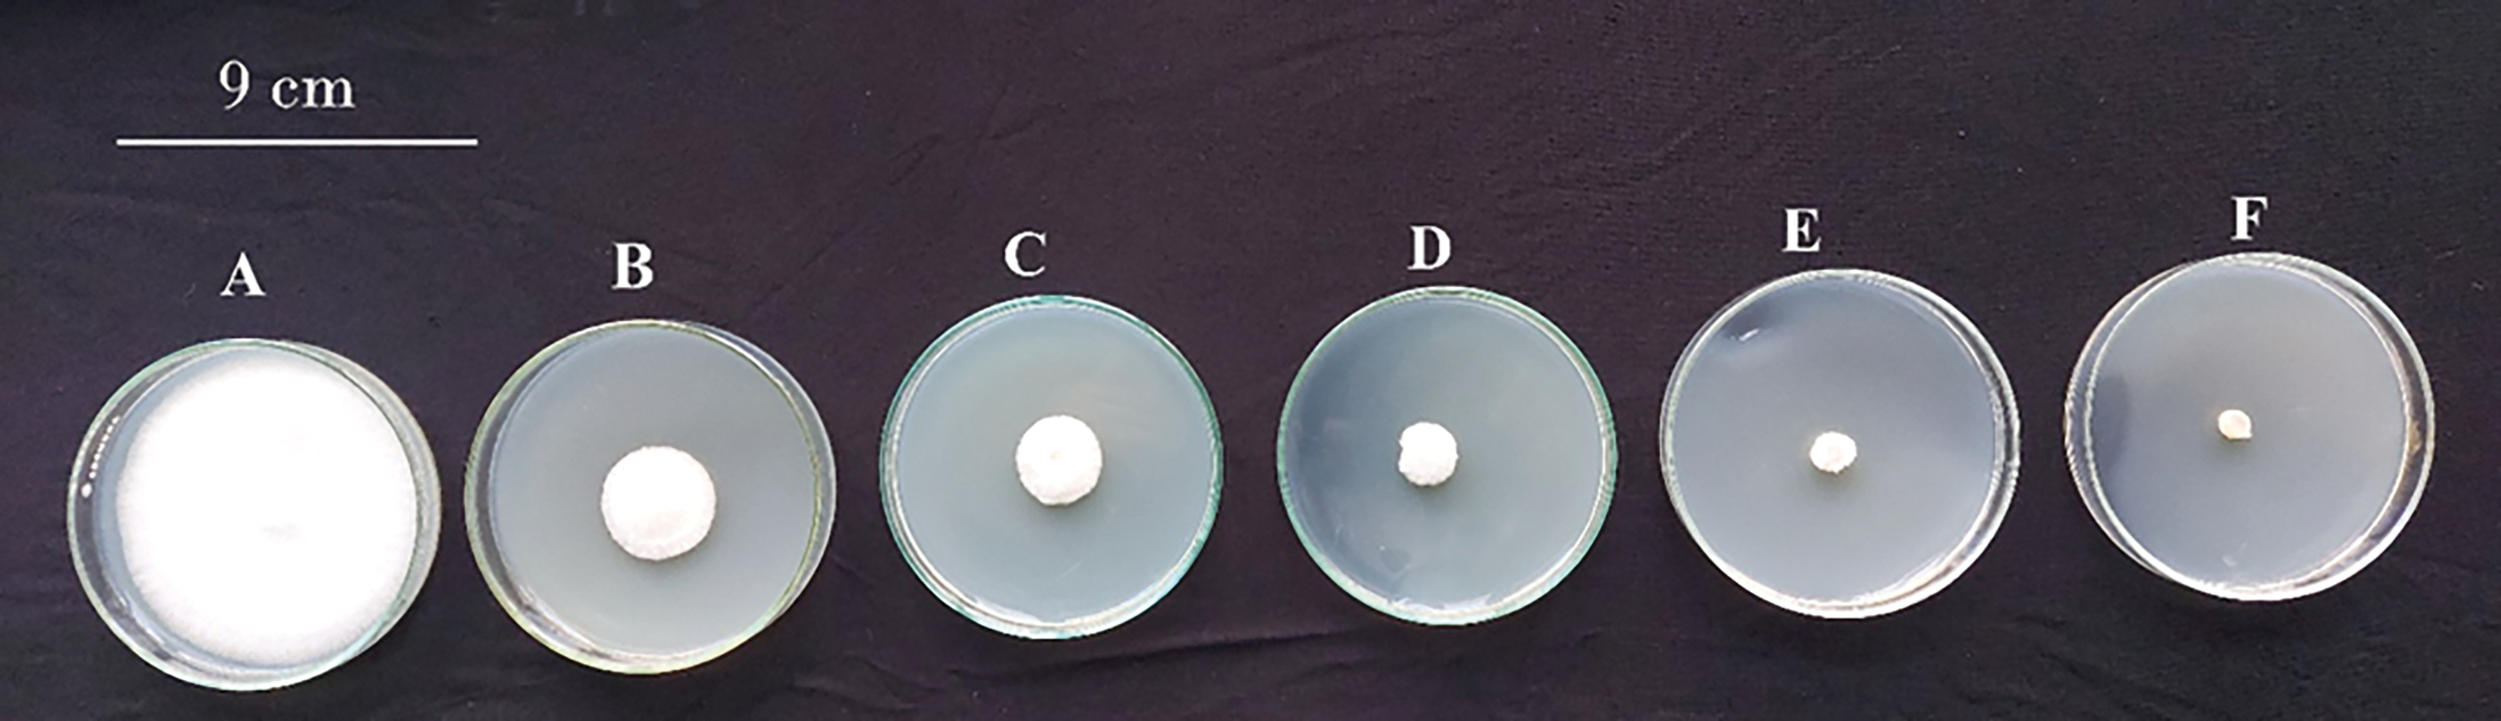
images

Open Access
ARTICLE
Effects of Paclobutrazol Seed Priming on Seedlings Quality, Physiological and Bakanae Disease Index Characteristics of Rice (Oryza sativa L.)
1 Agricultural Biotechnology Department, College of Agriculture and Food Sciences, King Faisal University, Al-Ahsa, 31982, Saudi Arabia
2 Biochemistry Department, Faculty of Agriculture, Cairo University, Gamma St, Giza, 12613, Egypt
3 Department of Agricultural Botany, Faculty of Agriculture, Kafrelsheikh University, Kafr El-sheikh, 33516, Egypt
4 Plant Virology Department, Plant Pathology Research Institute, Agriculture Research Center, Giza, 12619, Egypt
5 Rice pathology Department, Plant Pathology Research Institute, Agricultural Research Center (ARC), Kafr El-Sheikh, 33717, Egypt
6 Rice Research and Training Centre, Field Crops Research Institute, Agricultural Research Centre, Kafr El-Sheikh, 33717, Egypt
7 Department of Arid Land Agriculture, College of Agriculture and Food Sciences, King Faisal University, Al-Ahsa, 31982, Saudi Arabia
8 Crop Physiology Research Department, Field Crops Research Institute, Agricultural Research Center, Kafr El-Sheikh, 33717, Egypt
9 Plant Pathology Research Institute, Agricultural Research Centre (ARC), Giza, 12619, Egypt
* Corresponding Author: Hossam S. El-Beltagi. Email:
(This article belongs to the Special Issue: Influence of Biotic and Abiotic Stresses Signals on Plants and their Performance at Different Environments)
Phyton-International Journal of Experimental Botany 2024, 93(10), 2535-2556. https://doi.org/10.32604/phyton.2024.056734
Received 29 July 2024; Accepted 10 October 2024; Issue published 30 October 2024
Abstract
Rice (Oryza sativa L.) is one of the most important cereal crops in the world. Bakanae disease is a significant rice disease widely distributed in rice-growing regions worldwide. Therefore, the present investigation aimed to assess the optimal concentrations of paclobutrazol (PBZ) as a treatment for rice grains (cv. Sakha 108) to control bakanae disease, also evaluating its impact on grain germination, seedling growth parameters as well as disease index. Paclobutrazol concentrations had no significant impact on seed germination, regardless of whether the seeds were incubated with Fusarium fujikuroi or not. Application of PBZ, either alone or in combination with fungal pathogens, negatively impacted the rice seedlings’ height. Paclobutrazol at 25, 50 and 100 mg/L, combined with the fungal pathogen positively impacted root length. Paclobutrazol at 3 and 6 mg/L mitigated the adverse impact on chlorophyll pigments content in infected seedlings. The highest proline contents were achieved by 100 mg/L PBZ alone or in combination with fungal pathogens. It has been observed that the application of PBZ, either alone or in combination with a fungal pathogen, leads to the enhancement of catalase, peroxidase, and polyphenol oxidase activities. The median lethal concentration of PBZ was 0.874 mg/L; applying low concentrations of paclobutrazol effectively increased the percentage of fungal growth suppression. Application of PBZ, at higher concentrations (50 and 100 mg/L), decreased infection percentage and disease severity index (DSI) significantly. These findings suggest that PBZ can be an effective treatment for controlling bakanae disease and enhancing resistance in rice plants.Keywords
Nomenclature
| O. sativa | Oryza sativa |
| F. fujikuroi | Fusarium fujikuroi |
| PBZ | Paclobutrazol |
| GA | Gibberellin |
| °C | Degree celsius |
| ml | Milliliter |
| min | Minute |
| vol | Volume |
| h | Hour |
| CFU | Colony forming units |
| mg/L | Milligram/litter |
| C | Colony diameter (mm) of control |
| T | Colony diameter of treated plate |
| PDA | Potato dextrose agar |
| Cm | Centimeter |
| LC50 | Lethal concentration 50 |
| FGP | Final germination percentages |
| CO2 | Carbon dioxide |
| H2O2 | Hydrogen peroxide |
| PAR | Photo-synthetically active radiation |
| LTR | Leaf transpiration rate |
| μmol g−1 | Micromole/gram |
| chl. a | Chlorophyll a |
| chl. b | Chlorophyll b |
| CAT | Catalase |
| POD | Peroxidase activity |
| PPO | Polyphenol oxidase |
| DSI | Disease severity index |
| IAA | Indole acetic acid |
| GAs | Gibberellins |
| ABA | Abscisic acid |
Rice is a major staple food crop that feeds more than half of the world’s population. It provides the majority of calories for billions of people, particularly in Asia, Africa, and Latin America [1–3]. Fusarium fujikuroi Nirenberg, a teleomorph known as Gibberella fujikuroi (Sawada) Wollenw., is the cause of bakanae, or foolish seedling disease of rice. There have been reports of rice production losses worldwide, ranging from 20% to 50% [4]. According to reports, seeds are the main source of Bakanae disease [5]. As well as the fungus that causes the disease is soil- and seed-borne. According to Chen et al. [6], the disease is primarily transmitted from one field to another through infected seeds. An essential component in understanding the spread of rice diseases is the recovery percentage of pathogens in different parts of the rice grain. According to Manandhar [7], the lemma had the highest pathogen recovery percentage, followed by palea, basal glumes, embryo, or endosperm. This implies that the lemma is the most likely part where the fungus will flourish and proliferate.
Bakanae disease symptoms can vary according to a number of circumstances, including age, cultivar resistance, and stress levels. Since younger plants are more vulnerable to infection and the effects of the fungus’s gibberellin synthesis, symptoms are typically more noticeable in these plants. In general, severe bakanae symptoms are more likely to arise in stressed or weak plants [8]. Poor seedling emergence, elongated rice seedlings, fewer and thinner tillers, yellowish green leaves, crown rot, stunting, empty panicles, discolored grains, and possible wilting that resulted in plant mortality were among symptoms of the disease [4,9]. According to Wulff et al. [10], F. fujikori causes a lower percentage of seeds to germinate than other Fusarium species. Furthermore, numerous metabolites are produced by this pathogen, such as pigments like Bikaverin, mycotoxins, fusarins, fusaric acid, fusarubins or phytohormones, i.e., gibberellic acid [11,12]. Although all Fusarium species can impair seed germination and produce grain discoloration, Fusarium fujikori is thought to be more harmful than other species [10].
Synthetic growth inhibitor paclobutrazol (PBZ) is a member of the triazole chemical family. One of the most popular plant growth regulators in crop production is PBZ, a type of plant gibberellin (GA) biosynthesis inhibitor that may be applied as foliar spray or as soil drench that is absorbed by the roots. Depending on the desired outcome and type of plant, this flexibility enables the use of various application tactics [13]. According to Sponsel [13], PBZ prevents the oxidation of ent-kaurene, which inhibits the formation of GA (Anti-gibberellin). Additionally, it acts as a highly effective systemic fungicide and is utilized to treat a variety of economically significant fungal diseases [14]. Normally, seeds are treated with fungicides to control fungus disease. Seed priming is a pre-sowing treatment that is regarded as a cost-effective or convenient approach for improving crop production [15].
The infection mechanism of Bakanae disease depends on the enhanced production of gibberellin, leading to the accelerated growth of rice seedlings that are affected. Meanwhile, paclobutrazol inhibits gibberellin synthesis in the host plant, suggesting that it may also suppress gibberellin production in the pathogen. Utilizing specific concentrations of paclobutrazol could be key in managing the disease or at least mitigating its severity. Therefore, the current study was conducted to assess and determine the most effective PBZ concentrations for grain treatment against bakanae disease, as well as grain germination and seedling growth parameters.
Fusarium fujikuroi strain was isolated, purified and identified by Rice Pathology Department, Plant Pathology Research Institute, Agricultural Research Center (ARC), Kafr El-Sheikh, Egypt.
2.2 Preparation of F. fujikuroi Inoculum for Artificial Inoculation
200 g corn meal: sand (1:5, vol/vol) medium in Glass bottles of 500 mL capacity was autoclaved for 30 min. at 1.5 or 2 atm, then inoculated with 3 mycelial plugs (5 mm in diameter) from edges of 7-day old F. fujikuroi culture and incubated at 25°C for 10 days/12 h illumination to induce sporulation [16].
2.3 Preparation of Conidial Suspension
F. fujikuroi isolate was cultured on sandy media for micro conidia spore production and incubated at 28 ± 2°C for approximately 15–20 days. A flask was filled with sterilized water and a sterile brush was used to remove the conidia that was growing. Muslin cloth was used to filter the conidial suspension, which was then adjusted to 5 × 106 conidial/mL using hemocytometer [17].
2.4 Screening Paclobutrazol Concentration
A wide range of paclobutrazol concentrations was used to determine the appropriate levels that may affect F. fujikuroi while maintaining the viability of the rice plant. As a first stage, effect of paclobutrazol on F. fujikuroi on medium was assessed at the following concentrations (0, 1.5, 3, 6, 12, 25, 50, 100, 150, 200, 250 and 500 mg/L). Relative to the outcomes, further experiments employed concentrations of no more than 100 mg/L. The activity of PBZ was investigated in terms of mycelial growth, colony forming units (CFU), and F. fujikuroi sporulation. The effect of PBZ on hyphal growth was investigated by adding previously indicated PBZ doses to potato dextrose agar (PDA). F. fujikuroi was inoculated onto PBZ-improved agar plates by inserting a 5 mm diameter disc from the margins of 5-day-old colonies into the center of each plate. Five replicate plates were utilized for each treatment. Following a period of seven days, colony diameter measurements were taken in order to determine the percentage of inhibition. This was done utilizing the following formula according to Aurangzeb et al. [18].
percentage of inhibition =
where C = colony diameter (mm) of control, T = colony diameter of the treated plate.
Relative to the outcomes, further experiments employed concentrations of no more than 100 ppm. An estimation of the LC50 value was performed using probit analysis, according to Lei and Sun [19].
2.5 Preparation of Infected Seeds
Rice seeds (Sakha, 108) underwent multiple washes in sterile distilled water for approximately 5 min each. This washing process was repeated 3–4 times. Afterward, the cleaned seeds were left to dry in a clean area for about 1 h. Next, they were immersed in spore suspension of F. fujikuroi at varying concentrations and kept at a temperature of 25°C overnight to facilitate the attachment of conidia to the seed surface. Following this, the infected seeds were air-dried for an additional hour.
2.6 Hydroponic Germination System and Pots Experiments
Hydroponic germination system and pots experiments were carried out at Research Field of Rice, Research Department, Sakha Research Station Agricultural Research Center (ARC), Giza, and laboratories of Agricultural Botany Department, Faculty of Agriculture, Kafrelsheikh University, Egypt, on rice variety namely (Sakha 108) under greenhouse conditions. The experiments were conducted in order to study the effect of paclobutrazol (PBZ) at 1.5, 3, 6 12, 25, 50, 100 mg/L and its interaction with bakanae disease (Fusarium fujikuroi) on pathological, morpho-physiological, biochemical or histological characters of rice at the seedling growth stage.
2.6.1 Hydroponic Germination System Experiment
A new hydroponic germination system of rice grains has been developed in order to observe the response of grain germination, seedlings growth and bakanae disease and its symptoms to PBZ concentrations. Two plastic containers (dishes) were used, one large (9 cm × 9.5 cm and 5 cm in deep) and the other small (7 cm in diameter and 4.5 cm in deep), as shown in the following diagram (Fig. 1). The base of the small container was removed, and a hole (3 cm × 3 cm) was made in the lid. One end of a strip of medical gauze was attached to the area of the hole, with the other end hanging down. The small container was placed inside the large one, which was filled with water up to about halfway. The inculated and uninoculated rice grains (20 grains) were placed in the area of the hole in the lid of the small container. Water is drawn up through capillary action to the rice grains. After germination, the roots grow downward, permeating the medical gauze.

Figure 1: A hydroponic germination system was designed for rice germination and early seedling growth parameters measurements (A) and illustrating diagram (B)
The number of germinating seeds was counted every 2 days up to 15 days and considering grains germinated when the plumule emerged. At the end of the germination period, the final germination percentages (FGP), according to Kader [20].
Pots experiments were performed to study the effects of PBZ at 0, 1.5, 3, 6, 12, 25, 50, and 100 mg/L and its interaction with Fusarium fujikuroi inoculation on seedling growth parameters including seedling height, root length, dry weight, chlorophyll pigments, proline content, antioxidant enzymes, leaf CO2, Leaf H2O2, net photosynthesis, transpiration rate as well as stomata conductance. Rice grains were planted in 20 cm (in diameter) plastic pots filled with clay soil. Rice grains were inoculated with F. fujikuroi in different PBZ concentrations. PBZ-treated rice grains with and without F. fujikuroi inoculation were sown, 20 grains/pots of equally distant-spaced plants per pot. Pots were immersed in water up to 4 cm above the soil surface. The germinated seeds were counted from the second day to the eighth day.
2.7.1 Seedling Growth Parameters
For seedlings growth parameters, samples were taken after 30 days from sowing to estimate the root length, seedling height (cm), and dry weights of seedlings (dried in an electric oven at 70°C for 72 h) g/plant. Ten randomly selected plants were marked from each replicate (3 replicates/treatment), and evaluations were conducted on them.
2.7.2 Transpiration Rate, Stomata Conductance, Leaf CO2 and Net Photosynthesis
Assessing a plant’s carbon (C) and water content involves evaluating stomata, diffusive conductance, and exchange rates of CO2 or water vapor. To accomplish this, a portable porometer called the “steady-state porometer, LICOR, LI-1600, Lincoln, NE, USA” is employed. This porometer utilizes open gas exchange system that measures levels of incoming and outgoing CO2 and H2O2 concentrations in a cuvette placed on or around leaves [21]. Stomatal conductance (cm−2S−1) is measured in fully expanded leaves, while the net photosynthetic rate (NPR, A) (g m−2) utilized for gs models is estimated as follows: A = Amax × f (PAR), where PAR (photo-synthetically active radiation) is obtained from on-site measurements taken in the morning, around noon, and in the afternoon. CO2 concentration is calculated, and leaf transpiration rate (LTR) (μg cm−2 s−1) is directly measured on the same leaf, representing the combined rates of adaxial and abaxial surfaces. Additionally, this device can be used to determine the response of CO2 curves in field. Adaxial and abaxial diffusive resistances are evaluated on the upper fully expanded leaf using the steady-state porometer during the measurement process.
The second leaf from the tips of 10 rice seedlings/replicate (3 replicates/treatment) was collected to measure the endogenous hydrogen peroxide (H2O2) content (μmol g−9 fresh weight), following the method described by Velikova et al. [22].
The concentration of chlorophyll pigments (chl. a, b or total chlorophyll) (µg/cm2) were estimated as a fresh area from the second leaf tip from 10 seedlings/replicate (3 replicates/treatment) using a spectrophotometer according to Moran and Porath [21].
The proline content (µmol g−1) as a fresh weight in rice leaves (the second leaf from the seedling tip) was measured according to Bates et al. [23].
To conduct antioxidant enzyme assays, rice leaves that had been frozen were finely ground into powder using liquid nitrogen. The ground powder was then extracted using ice-cold 0.1M Tris-HCl buffer (pH 7.5), which also contained 5% (w/v) sucrose and 0.1% 2-mercaptoethanol, (3:1 buffer volume/FW). After homogenization, the mixture was subjected to centrifugation at 10,000 g for 20 min at a temperature of 4°C. Resulting supernatant was utilized for determining enzyme activity. Both the preparations for enzyme extraction and the enzyme assay itself were carried out at a temperature of 4°C.
The activity of Catalase, CAT (EC 1.11.1.6) was estimated by monitoring the disappearance of H2O2 at 240 nm according to Aebi’s method [24]. Peroxidase activity, POD (EC 1.11.1.7) was measured according to Polle et al. [25]. Polyphenol oxidase, PPO (EC 1.14.18.1) activity was detected using the technique of Oktay et al. [26].
2.7.7 Evaluation of Paclobutrazol on Appearance of Bakanae Disease
The Bakanae disease severity index (DSI) was assessed in ten seedlings per replicate (3 replicates/treatment) at 30 days post-treatment using the disease severity scale (DSS), as described by Mohd Zainudin et al. [27].
Data were calculated utilizing analysis of variance (ANOVA). Means were considered significantly different when the significance level (p) was equal to or less than 0.05. All calculations were determined as described by the statistical package of the Costate Program (1986). Duncan’s multiple range tests were utilized to compare treatment means [28].
3.1 Influence of PBZ Concentrations on F. fujikuroi Growth in Vitro
Figs. 2 and 3 indicate that paclobutrazol exhibited inhibitory effects on mycelial growth of F. fujikuroi in a dose-dependent manner. At concentrations of 1.5, 3, 6, 12 and 25 mg/L, paclobutrazol likely had some inhibitory effect on radial mycelial growth of F. fujikuroi, while the reduction may have been significant compared to the control. However, at concentrations of 12, 25, 50, and 100 mg/L, paclobutrazol had a more pronounced effect on mycelial growth. Specifically, at concentrations of 50 and 100 mg/L, paclobutrazol significantly reduced the linear growth of F. fujikuroi. This indicates that these concentrations were the critical doses at which paclobutrazol had a significant impact on the linear expansion of the fungal mycelium.
Figure 2: Effect of PBZ at various concentrations on linear growth of Fusarium fujikuroi at 7 days from incubation under lab conditions using potatodextrose agar media A: 0 mg/L, B: 1.5 mg/L, C: 3 mg/L, D: 6 mg/L, E: 12 mg/L and F: 25 mg/L

Figure 3: Effect of PBZ at different concentrations at 0, 1.5, 3, 6, 12, and 25 mg/L on linear growth of Fusarium fujikuroi at 7 days from incubation. Letters that differ on each bar indicate significant contrast among treatments (p < 0.05)
In lethal concentration 50 (LD50), the doses of toxic substances that result in the death of a certain proportion of organisms are often used as indicators of acute toxicity. The Probit analysis findings indicate that the estimated median lethal concentration (LD50) of PBZ was determined to be 0.847 mg/L. This value suggests that at low dosages of PBZ, it has ability to suppress mycelial development of F. fujikuroi (Table 1, Fig. 4).


Figure 4: Effect of paclobutrazol fungicide on the inhibition of mycelial growth of F. fujikuroi in vitro sensitivity test with probit analysis
Rice seeds priming with paclobutrazol (PBZ) at 100, 50, 25, 12, 6, 3, 1.5 and 0 mg/L with and without Fusarium fujikuroi incubation insignificantly impacted seed germination percentage (Fig. 5).

Figure 5: Rice seed germination percentage as affected by priming with PBZ at 100, 50, 25, 12, 6, 3, 1.5 and 0 mg/L concentrations with and without F. fujikuroi incubation after 4 weeks from seed sowing
The data presented in Figs. 6 and 7 demonstrated that seed priming with PBZ at oncentrations of 1.5, 3, 6, 12, 25, 50, and 100 mg/L significantly reduced rice seedling height compared to the control. There was an inverse relationship between increasing PBZ concentrations and seedling height reduction. Additionally, a significant increase in seedling height was observed in rice seeds inoculated with F. fujikuroi compared to uninoculated seedlings when combined with PBZ application.

Figure 6: Rice seedling height as affected by priming with PBZ at 100, 50, 25, 12, 6, 3, 1.5 and 0 mg/L concentrations with (Infected) and without (Healthy) F. fujikuroi incubation after 4 weeks from sowing. Letters that differ on each bar indicate significant contrast among treatments (p < 0.05)

Figure 7: Effect of seed priming with various concentrations of paclobutrazol (PBZ) at 0, 1.5, 3, 6, 12, 25, 50 and 100 mg/L with (A) and without (B) F. fujikuroi inoculation on seedling height at 4 weeks after sowing
3.5 Root Length and Lateral Roots Initiation
There is a negative relationship between increasing paclobutrazol (PBZ) concentrations and a reduction in root length. On the other side, a positive relationship was noted between the application of PBZ concentrations in combination with F. fujikuroi inoculation on root length (Fig. 8). It was noted that PBZ at 12 mg/L increased the initiation of lateral roots (Fig. 9).

Figure 8: Effect of seed priming with different concentrations of paclobutrazol (PBZ) at 0, 1.5, 3, 6, 12, 25, 50 and 100 mg/L F. fujikuroi inoculation on root length at 4 weeks after sowing in the hydroponic system

Figure 9: Effect of paclobutrazol (PBZ) at different concentrations on initiation of lateral roots at 2 weeks after seed sowing in hydroponic germination system, A: 0 mg/L, B: 1.5 mg/L, C: 3 mg/L, D: 6 mg/L, E: 12 mg/L and F: 25 mg/L at 2 weeks after seed sowing, Lr: lateral roots
3.6 Shoot and Root Dry Weight/Seedling
Data illustrated in Fig. 10 showed that treating plants with PBZ resulted in a significant reduction in both shoot and root dry weight values. The trend of decreasing shoot and root dry weight with increasing PBZ concentration was observed not only in the uninoculated plants but also under the inoculated condition. This suggests that the inhibitory effect of PBZ on shoot and root growth was consistent regardless of whether the plants were inoculated with F. fujikuroi. It is noted that, the interaction between PBZ and the inoculation with F. fujikuroi, resulting in lower root dry weight values compared to PBZ treatment alone.

Figure 10: Effect of paclobutrazol (PBZ) at (0, 1.5, 3, 6, 12, 25, 50 and 100 mg/L) on shoot and root dry weight/plant at 4 weeks after seed sowing. Letters that differ on each bar indicate significant contrast among treatments (p < 0.05)
Besides morphological effects, paclobutrazol also directly contributes to different physiological changes that are generally associated with optimized yield in different crops. Data illustrated in Fig. 11 revealed that PBZ at all used concentrations significantly increased chlorophyll content (chl. a, b or total) in comparison with the control. The highest chlorophyll content values were recorded at 6 and 3 mg/L PBZ treatments. It is noted that the interaction between PBZ and the inoculation with F. fujikuroi, resulting in lower chlorophyll a, chlorophyll b, or total chlorophyll values compared to the application of PBZ alone. When combined with F. fujikuroi inoculation, PBZ concentrations still significantly increased the content of chlorophyll pigments. However, the highest chlorophyll content was observed at a 12 mg/L PBZ concentration.

Figure 11: Effect of paclobutrazol (PBZ) at different concentrations and its combination with F. fujikuroi inoculation on chlorophyll pigments content of rice seedling at 4 weeks after sowing, (A) Chlorophyll a, (B) Chlorophyll b and (C) Total chlorophyll. Letters that differ on each bar indicate significant contrast among treatments (p < 0.05)
Rice seedlings treated with both PBZ and its interaction with F. fujikuroi inoculation exhibited higher proline concentrations than untreated seedlings. There is a link between increasing concentrations of PBZ and an increase in proline content in plants. This means that as PBZ concentration increased, the proline content in the plant also increased. The highest proline contents were detected by PBZ at 100 mg/L with and without fungal pathogen inoculation (Fig. 12). It is noted that the application of PBZ in combination with F. fujikuroi inoculation resulted in higher proline contents compared to uninoculated treatments.

Figure 12: Effect of paclobutrazol (PBZ) at different concentrations (mg/L) and its combination with F. fujikuroi inoculation on proline concentration of rice seedling at 4 weeks after sowing. Letters that differ on each bar indicate significant contrast among treatments (p < 0.05)
Data in Fig. 13 indicated that it appears that there is a relationship between the concentration of PBZ and activity of antioxidant enzymes, including catalase (CAT), peroxidase (POD) and polyphenol oxidase (PPO). As the concentration of PBZ increases, the activity of these enzymes also increases. Significant differences were detected on CAT, POD and PPO activity between inoculated and uninoculated treatments without PBZ application (0 mg/L). More enzymes activities were noted in inoculated seedlings than uninoculated ones. Furthermore, when PBZ was applied, significant variances in enzyme activity were observed between inoculated and uninoculated treatments. Inoculated seedlings showed higher enzyme activity compared to uninoculated seedlings, even under PBZ application.

Figure 13: Effect of paclobutrazol (PBZ) at different concentrations (mg/L) and its combination with F. fujikuroi inoculation on antioxidant enzymes activity in rice seedling at 4 weeks after sowing, (A) Catalase, (B) Peroxidase and (C) Polyphenol oxidase (P.P.O). Letters that differ on each bar indicate significant contrast among treatments (p < 0.05)
During photosynthesis, plants absorb carbon dioxide (CO2) from the atmosphere through the stomata, which is necessary for photosynthesis process. Data in Fig. 14A indicated that insignificant differences were detected in CO2 around the leaf between inoculated and uninoculated rice seedlings under 0 mg/L PBZ. While significant increases in leaf CO2 exchange rates were recorded by 12, 50 and 100 mg/L PBZ without fungus inoculation. The data from Fig. 13 suggests that there were no significant differences in CO2 around the leaf levels between inoculated and uninoculated rice seedlings under the treatment of 0 mg/L PBZ.

Figure 14: Effect of paclobutrazol (PBZ) at different concentrations (0, 1.5, 3, 6, 12, 25, 50 and 100 mg/L) and its combination with F. fujikuroi inoculation on CO2 around leaf (μmol m−2 s−1) (A), stomatal conductance (cm−2 s−1) (B), transpiration rate (μg cm−2 s−1) (C), leaf H2O2 (μmol m−2 s−1) (D) and net photosynthesis (g m−2) (E) of rice seedling at 4 weeks after sowing
Stomatal conductance plays a crucial role in both photosynthesis and transpiration. Higher conductance allows more CO2 for photosynthesis but also leads to more water loss through transpiration. It is influenced by various factors, including environmental conditions, such as light intensity, temperature, humidity, and concentration of CO2 in the atmosphere. Data in Fig. 14B revealed that PBZ treatments without F. fujikuroi inoculation (Healthy) gave the highest stomatal conductance values compared with inoculated rice seedlings except PBZ at 12 mg/L. Inoculated rice seedlings recorded the lowest stomatal conductance value without PBZ application.
Transpiration is an essential process for plants, as it facilitates the movement of water and nutrients from the roots to the leaves. However, excessive transpiration without adequate water uptake can lead to water stress and negatively impact plant growth. Data in Fig. 14C revealed that inoculated seedlings gave the lowest transpiration rate value. Under most PBZ concentrations, significant increases in transpiration rates were noted by inoculated seedlings compared to uninoculated rice seedlings.
Data in Fig. 14D indicated that the highest leaf hydrogen peroxide (H2O2) content values were noted by most PBZ treatments without inoculation.
Data in Fig. 14E revealed that net photosynthesis values were found by all PBZ concentrations without F. fujikuroi inoculation.
Data in Fig. 15 illustrated disease index, including infection %, efficiency and disease severity index (DSI) in both hydroponic and pots experiments. An inverse relationship was observed between PBZ concentrations and infection % and disease severity index (DSI). PBZ at 50 and 100 mg/L gave the lowest values. At the same time, a positive relationship was found between PBZ concentrations and disease efficiency. This means that increasing the concentration of PBZ increases efficiency. Decreasing in infection % and DSI due to paclobutrazol acts as fungi growth inhibitor. The positive impact on infection percentage suggests that PBZ treatment, particularly at higher concentrations, increased the tolerance and/or resistance ability of the rice plants to infection by the fungal pathogen.

Figure 15: Effect of PBZ at 0, 1.5, 3, 6, 12, 25, 50 and 100 mg/L in combination with F. fujikuroi inoculation on infection % and disease severity index (DSI) in hydroponic and pots experiments. Letters that differ on each bar indicate significant contrast among treatments (p < 0.05)
The median lethal dose (LD50) is a commonly used measure, and it represents the dose at which 50% of the population being studied is expected to die. LD50 values are useful in assessing the relative toxicity of different substances, as substances with lower LD50 values are considered more toxic than those with higher LD50 values. LD50 values provide valuable information for evaluating the potential risks associated with exposure to toxicants in various organisms, i.e., fungal organisms [29]. Paclobutrazol can have inhibitory effects on mycelial growth in some fungi. Martínez et al. [30] indicated that Paclobutrazol at 0.05, 0.25, 1.25, and 6.25 mg/L reduced mycelial growth of Botrytis cinerea isolates. This may be due to its ability to interfere with the biosynthesis of gibberellins, a group of plant hormones that are involved in regulating plant growth or development. By suppressing gibberellin production, paclobutrazol can inhibit the elongation of fungal hyphae, thereby affecting mycelial growth. Additionally, the concentration of paclobutrazol used and the duration of exposure can also influence its effects on mycelial growth. However, the efficacy of paclobutrazol as a fungicide may vary depending on the specific fungus, its life stage, and other environmental factors. Phenamacril and ipconazole (triazole compounds) are both antifungal compounds that have been tested for their activity against F. fujikuroi mycelial growth. When tested individually, both phenamacril and ipconazole demonstrated high antifungal activity against F. fujikuroi mycelial growth. Ipconazole is a triazole fungicide that acts by inhibiting the biosynthesis of ergosterol, a key component of fungal cell membranes. Without ergosterol, the integrity of the fungal cell membrane is compromised, leading to cell death. Ipconazole has demonstrated potent antifungal activity against a wide range of fungal pathogens, including F. fujikuroi [31].
Our results showed minimal changes in seed germination for both incubated and non-incubated rice seeds, which were not statistically significant (Fig. 5). Applying growth regulators like paclobutrazol to seeds can indeed lead to several challenges, including reduction or absence of seed germination and/or delay in seedling [15]. On the other hand, Dewi et al. [32] found that paclobutrazol at 12.5, 25. 50 and 100 mg/L concentrations did not affect black rice seed germination %. The effect of paclobutrazol on seed germination percentage may be depends on plant species and the concentration used as well as incubation period. Soaking tomato seeds in paclobutrazol (PBZ) solutions, even at relatively low concentrations like 500 and 1000 mg L−9, can indeed decrease germination compared to water-soaked control seeds [33]. The fact that the germination process is not affected by treatment with the different concentrations of paclobutrazol is a key point for its use in combating the bakanae disease in rice.
The reduction in rice seedling height may indeed be explained by significant and irreversible enlargement of small daughter cells resulting from meristematic cell divisions. Furthermore, reduction rates of new cell production can further contribute to suppressing seedling growth. As a result, both cell enlargement or division are inhibited, ultimately decreasing overall seedling growth parameters. There is a strong correlation between PBZ application and a reduction in plant growth [34,35]. Moreover, this effect may be attributed to decreased net photosynthetic plant rates due to the reduction in photosynthetic leaf area. Paclobutrazol (PBZ) is synthetic growth retardant and is known as anti-gibberellins [36,15]. It works by inhibiting the biosynthesis of gibberellins, which are plant hormones that promote stem elongation. The increase in seedling height observed in inoculation with F. fujikuroi could be attributed to the strain potentially producing gibberellin-like substances, which promote stem elongation [37]. Paclobutrazol at 1.5, 3, 6, 12, 25, 50 and 100 mg/L combined with F. fujikuroi inoculation decreased rice shoot height compared to infected and untreated plants. The highest reduction in seedling height was recorded at 50 and 100 mg/L PBZ. Paclobutrazol (PBZ) is known as a plant growth regulator. Its main function is to inhibit the production of gibberellins (GAs), which are plant hormones that promote growth and development. By reducing GA levels, PBZ can stunt plant growth [15]. Under PBZ application, the inoculation of F. fujikuroi resulted in an increase in shoot length compared to uninoculated seedlings. This indicates that the combination of PBZ application and F. fujikuroi inoculation had a positive impact on shoot growth. It is possible that F. fujikuroi infection may induce physiological changes or produce compounds that interfere with the normal growth processes regulated by PBZ.
An inverse relationship was observed between higher PBZ concentrations and a decrease in root length. Conversely, a positive correlation was found when PBZ were applied in combination with F. fujikuroi inoculation, resulting in increased root length. PBZ was observed to increase the diameter and length of fibrous roots and enhance lateral root formation in Catharanthus roseus plants [38]. Li et al. [39] indicated that PBZ at 6 mg/L significantly increased the lateral root number of Phoebe bournei. There is a correlation between an increase in number of lateral roots and an enhancement indole acetic acid (IAA) level. Auxin is essential for regulating the development and growth of roots. Indole acetic acid (IAA) plays a role in controlling cell division and elongation, thereby regulating the growth of primary and lateral roots through polar auxin transport (PAT). Auxins have been extensively studied and consistently found to have the most pronounced effect on rooting processes. They play a crucial role in stimulating cell division and elongation, promoting the formation and development of roots [40]. This process involves the formation of asymmetric distribution and concentration gradients of IAA in the roots.
At the same time, PBZ’s ability to regulate root growth is achieved by modulating balance of crucial endogenous plant hormones, such as gibberellic acid (GA) and abscisic acid (ABA) [41,42]. As the concentration of paclobutrazol (PBZ) increased abscisic acid (ABA) levels in P. bournei roots initially decreased significantly and then increased. This dynamic fluctuation was closely associated with ABA biosynthesis and metabolism processes [43]. ABA exhibits different effects on root regulation depending on its concentration. At low concentrations, ABA promotes root growth. However, at high concentrations, it inhibits root development [44].
The reduction in seedling dry weight observed in the presence of PBZ can be attributed to inhibition of gibberellin (GA) biosynthesis. As mentioned earlier, PBZ acts by reducing the production of GAs, which are plant hormones that promote growth [15]. By inhibiting GA production, PBZ can potentially reduce the leaf size and overall photosynthetic area of the plant. Reduced photosynthetic area can hinder the plant’s ability to capture sunlight and perform photosynthesis efficiently, which can further contribute to decreased biomass accumulation. The interaction between PBZ and the inoculation with F. fujikuroi, resulting in lower root dry weight. This indicates that the presence of F. fujikuroi had an additional impact on the reduction of root dry weight when combined with PBZ treatment. This suggests that, the reduction in root dry weight due to increasing ABA content [40]. At high concentrations, ABA can have a more pronounced inhibitory effect on root growth. The reduction in root dry weight suggests that the accumulation of ABA inhibits root biomass accumulation, potentially by interfering with cell division, elongation, or nutrient uptake processes [41]. The relationship between plant length (length of shoot and root) and dry weight is typically positive (Figs. 6, 8 and 10), indicating that as a plant becomes taller (with increased length), its overall biomass, including dry weight, generally increases as well.
Increasing chlorophyll content can be explained by more densely packed chloroplasts per unit leaf area due to a reduction in leaf area [42]. This could be due to an increase in the activity of oxidative enzymes (CAT, POX and PPO) that prevented cell maturation and cell death. PBZ-treated plants synthesized more cytokinin, which enhanced chloroplast development and chlorophyll biosynthesis or prevented chlorophyll catabolism [45,46]. The presence of F. fujikuroi may have contributed to the observed reduction in chlorophyll levels, potentially through mechanisms such as interference with chlorophyll synthesis or increased stress on the plants. On the other hand, PBZ synthesized more cytokinin, a class of plant hormones known for their role in promoting cell division and chloroplast development. This increased cytokinin synthesis, in turn, enhanced chloroplast development and chlorophyll biosynthesis in the treated plants [47,48]. Bakanae disease indeed causes various symptoms in rice plants, and etiolation is just one of them. This is the most characteristic symptom, causing abnormally thin leaves [9]. The fungus disrupts the pathways responsible for chlorophyll production, leading to less chlorophyll pigment being formed. Etiolation cases can involve accelerated breakdown of existing chlorophyll molecules. The fungus produces gibberellin-like compounds that mimic the plant hormone gibberellin. However, these fungal gibberellins disrupt the normal signaling pathways involved in chlorophyll production, leading to reduced synthesis [47]. Building on the known ability of paclobutrazol (PBZ) to inhibit gibberellin (GA) biosynthesis in plants, this study demonstrates that PBZ also reduces the growth of the rice pathogen Fusarium fujikuroi. This observed reduction in fungal growth suggests a potential link between PBZ’s mode of action and the inhibition of gibberellin-like compound biosynthesis within the fungus. Further investigation is needed to confirm this hypothesis and explore the underlying mechanisms in detail.
The interaction between PBZ and F. fujikuroi inoculation had synergistic effect on proline accumulation in plants. The higher proline contents observed under the combined PBZ and F. fujikuroi treatment suggest that the fungal inoculation induced a greater stress response in the plants, potentially leading to increased proline synthesis. Proline acts as an osmolyte, meaning it accumulates in response to PBZ treatment. This accumulation helps maintain cell turgor pressure by drawing water into the cell, preventing dehydration and collapse of the cell membrane [49]. PBZ can alter gibberellin (GA) metabolism, and a decrease in GA can indirectly lead to increased ABA biosynthesis [40]. Abscisic acid (ABA) plays a significant role in increasing proline content in plants [50]. In general, proline content values were higher in inoculated than uninoculated seedlings. The increase in proline could be due to the stress caused by fungal infection [51]. Proline plays a role in preserving chlorophyll content and leaf turgor while also improving stomatal conductance, all of which are linked to drought tolerance [52].
Paclobutrazol (PBZ) can indeed increase the activity of various antioxidant enzymes, i.e., catalase (CAT), peroxidase (POD), polyphenol-oxidase (PPO), etc., in plants [53,54]. These enzymes break down harmful reactive oxygen species (ROS) like H2O2, protecting cells from damage. This might be due to enhanced energy interception by photosynthetic pigments [55]. When plants are inoculated with F. fujikuroi, it triggers a defense response in the plants. As part of this defense response, the plants may increase the activity of antioxidant enzymes. Therefore, observed increase in antioxidant enzyme activity under F. fujikuroi inoculation suggests that the plants are mounting a defense response to counteract oxidative stress caused by the pathogen. This increase in enzyme activity helps to protect the plants and may contribute to their overall resistance against F. fujikuroi infection [56,57]. Under stress conditions, the activity of polyphenol oxidase (PPO) increases in plants. PPO is an enzyme involved in the oxidation and degradation of phenolic compounds, which often accumulated in plants as a response to stress [58]. The increased activity of PPO allows for oxidation of phenolic compounds, converting them into quinones. Quinones can then undergo further reactions, including polymerization, which helps to detoxify and degrade the phenolic compounds [55]. These enzymes mitigate ROS, protecting cells from damage. As a result, chlorophyll content tends to rise.
The presence of the fungal inoculation (F. fujikuroi) did not have a noticeable effect on CO2 around the leaf levels in the absence of PBZ treatment. However, significant increases in leaf CO2 exchange rates were observed when PBZ was applied at concentrations of 50 and 100 mg/L in the absence of fungal inoculation. The increased leaf CO2 exchange rates under PBZ treatment suggest that PBZ may have influenced the stomatal conductance of the rice seedlings. Stomatal conductance refers to the regulation of the stomata, which control the exchange of gases, including CO2. The relationship between gibberellins (GA) and abscisic acid (ABA) in regulating stomata opening and transpiration is well-established in plants. ABA signals the guard cells surrounding the stomata to close, reducing water loss through transpiration [59].
When environmental conditions are favorable, stomata open wider, allowing for increased gas exchange. This leads to higher stomatal conductance; Conversely, when unfavorable conditions, such as biotic and abiotic stress, stomata close partially or wholly to reduce water loss through transpiration. This results in lower stomatal conductance. The interaction between spraying time and paclobutrazol concentration significantly influences stomatal conductance in rain tree leaves [59]. In most plants, higher CO2 concentration inside the leaves typically increases stomatal activity [59]. It’s important to note that increasing transpiration under infection conditions can lead to dehydration and stress in plants. It’s important to note that while stomata conductance and transpiration rate are generally positively correlated, there can be exceptions depending on specific plant species, environmental conditions, and the plant’s physiological responses to different stress factors [59].
Hydrogen peroxide is reactive oxygen species (ROS) that is produced as a byproduct of various plants’ metabolic processes, including photosynthesis and respiration. Various abiotic and biotic stresses can trigger hydrogen peroxide (H2O2) accumulation in leaves. Under salinity conditions, it is common for the concentration of (H2O2) to increase significantly in leaf tissues. Salinity stress can disrupt the balance between reactive oxygen species (ROS) production and detoxification in plant cells, leading to an accumulation of ROS, including H2O2 [56]. The increased levels of H2O2 can activate defense mechanisms and antioxidant systems to mitigate the damage caused by stress factors. While hydrogen peroxide is a ROS, it may also cause oxidative stress if present in excess.
Both spraying time and paclobutrazol concentration significantly influenced the photosynthesis rate of raintree leaves. While higher stomatal conductance could indeed lead to increased CO2 diffusion and potentially boost photosynthesis [58]. PBZ-increased CO2 diffusion due to higher stomatal conductance can lead to a more active carboxylation reaction in the mesophyll cells, potentially boosting the photosynthesis rate [60]. PBZ can lead to increased ABA (abscisic acid) content in plants; the products of photosynthesis are directed toward roots, leading to dominant root growth [39]. A positive correlation between the significant decrease in CO2 concentration in rice leaves and a higher growth rate [61].
Triazole compounds, specifically triazole-based fungicides like triadimefon and propiconazole, are commonly used in agriculture to control fungal diseases in crops. This could be due to the potential influence of PBZ on plant defense mechanisms or the pathogen’s ability to overcome the plant’s natural resistance. However, their mode of action against pathogens is primarily through inhibiting synthesis of ergosterol, a key component of fungal cell membranes, rather than directly increasing the content of antioxidants in plants [62,63]. Application of paclobutrazol (PBZ), a plant growth regulator, can lead to increased concentrations of abscisic acid (ABA) in leaves. ABA is phytohormone that plays crucial role in different physiological processes in plants, including stomatal regulation, and responses to environmental stresses [15]. ABA is also associated with plant responses to various environmental stresses, such as salinity and cold temperatures. Increased ABA concentrations can trigger stress-related signaling pathways, leading to the activation of stress-responsive genes and the production of protective compounds. Additionally, certain triazole compounds may have indirect effects on plant defense mechanisms. For example, they might induce the production of defense-related hormones like jasmonic acid or enhance the activity of defense-related enzymes, which can indirectly contribute to plant resistance against biotic stresses [62]. The activity of antioxidant enzymes in plants is a key indicator of their ability to resist diseases and environmental stresses [55]. Elevated antioxidant enzyme levels often correlate with enhanced plant health, reduced disease severity, and greater resilience under stress conditions [64,65]. Therefore, improving antioxidant defenses through breeding or biotechnological approaches is an important strategy for enhancing plant resistance to diseases.
PBZ, whether used alone or in combination with F. fujikuroi inoculation, results in reduced seedling height but enhances several growth traits, including chlorophyll and proline levels, enzyme activity, and net photosynthesis. Additionally, low concentrations of PBZ are effective at inhibiting fungal growth. Moreover, a 100 mg/L concentration of PBZ notably reduces the rate of bakanae disease infection in rice seedlings. The findings emphasize the importance of paclobutrazol in reducing bakanae disease and enhancing growth traits under greenhouse conditions. However, a key question remains: Will paclobutrazol as a seed priming treatment provide substantial benefits for managing bakanae disease in field conditions? Additional research is required to answer this question.
Acknowledgement: Authors extend their appreciation to Deanship of Scientific Research, Vice Presidency for Graduate Studies and Scientific Research, King Faisal University, Saudi Arabia (KFU241897), for support this research work.
Funding Statement: This research work was supported and funded by Deanship of Scientific Research, Vice Presidency for Graduate Studies and Scientific Research, King Faisal University, Saudi Arabia (KFU241897).
Author Contributions: The authors confirm their contribution to the paper as follows: study conception and design: Mohamed Fathi El-Nady, Abdelaziz M. Tahoon, Metwaly Mahfouz Salem Metwaly, Dina Abdulmajid; data collection: Mohamed Fathi El-Nady, Abdelaziz M. Tahoon, Metwaly Mahfouz Salem Metwaly, Dina Abdulmajid; analysis and interpretation of results: Metwaly Mahfouz Salem Metwaly, Dina Abdulmajid, Hossam S. El-Beltagi, Adel A. Rezk, Mohammed I. Al-Daej, Mohamed M. El-Mogy, Elsayed Abd Elmaksoud Abomarzoka, Sherif Mohamed El-Ganainy; draft manuscript preparation: Mohamed Fathi El-Nady, Abdelaziz M. Tahoon, Metwaly Mahfouz Salem Metwaly, Dina Abdulmajid, Hossam S. El-Beltagi. All authors reviewed the results and approved the final version of the manuscript.
Availability of Data and Materials: Authors confirm that the data supporting the findings of this study are available within article.
Ethics Approval: Not applicable.
Conflicts of Interest: The authors declare that they have no conflicts of interest to report regarding the present study.
References
1. Rezk AA, El-Malky MM, El-Beltagi HS, Al-daej M, Attia KA. Conventional breeding and molecular markers for blast disease resistance in rice (Oryza sativa L.). Phyton-Int J Exper Botany. 2023;92(3):725–46. doi:10.32604/phyton.2023.024645. [Google Scholar] [CrossRef]
2. Rezk AA, Mohamed HI, El-Beltagi HS. Genetic variability and diversity analysis in Oryza sativa L. genotypes using quantitative traits and SSR markers. Saudi J Biol Sci. 2024;31(7):103944. doi:10.32604/phyton.2024.052739. [Google Scholar] [CrossRef]
3. Shallan MA, El-Beltagi HS, Mona AM, Amera TM. Chemical evaluation of pre-germinated brown rice and whole grain rice bread. Elect J Environ, Agri Food Chem. 2010;9(5):958–71. [Google Scholar]
4. Desjardins AE, Manandhar HK, Plattner RD, Manandhar GG, Poling SM, Maragos CM. Fusarium species from Nepalese rice and production of mycotoxins and gibberellic acid by selected species. Appl Environ Microbiol. 2000;66(3):1020–5. doi:10.1128/aem.66.3.1020-1025.2000. [Google Scholar] [PubMed] [CrossRef]
5. Sunani SK, Bashyal BM, Kharayat BS, Prakash G, Gopala KS, Aggarwal R. Identification of rice seed infection routes of Fusarium fujikuroi inciting bakanae disease of rice. J Plant Pathol. 2020;102(1):113–21. doi:10.1007/s42161-019-00390-8. [Google Scholar] [CrossRef]
6. Chen S, Lu X, Fang H, Perumal AB, Li R, Feng L, et al. Early surveillance of rice bakanae disease using deep learning and hyperspectral imaging. aBIOTECH. 2024;5(3):281–97. doi:10.1007/s42994-024-00169-1. [Google Scholar] [PubMed] [CrossRef]
7. Manandhar J. Fusarium moniliforme in rice seeds: its infection, isolation, and longevity/Fusarium moniliforme in reissamen: infektion, isolation und langlebigkeit. Zeitschrift für Pflanzenkrankheiten und Pflanzenschutz/J Plant Dis Prot. 1999;106(6):598–607. [Google Scholar]
8. Karthik C, Shu Q. Current insights on rice (Oryza sativa L.) bakanae disease and exploration of its management strategies. J Zhejiang Univ-Sci B. 2023;24(9):755–78 (In Chinese). doi:10.1631/jzus.B2300085. [Google Scholar] [PubMed] [CrossRef]
9. Bashyal BM. Etiology of an emerging disease: bakanae of rice. Indian Phytopath. 2018;71(9):485–94. doi:10.1631/jzus.B2300085. [Google Scholar] [CrossRef]
10. Wulff EG, Sørensen JL, Lübeck M, Nielsen KF, Thrane U, Torp J. Fusarium spp. associated with rice Bakanae: ecology, genetic diversity, pathogenicity and toxigenicity. Environ Microbiol. 2010;12(3):649–57. doi:10.1111/j.1462-2920.2009.02105.x. [Google Scholar] [PubMed] [CrossRef]
11. Tudzynski B. Biosynthesis of gibberellins in Gibberella fujikuroi: bimolecular aspects. Appl Microbiol Biotechnol. 1999;52:3. doi:10.1007/s002530051524. [Google Scholar] [PubMed] [CrossRef]
12. Barrett JE. Mechanisms of action. In: Gaston ML, editor. Tips on regulating growth of floriculture crops. Batavia: Ball Publishing; 2001. p. 32–47. doi:10.1186/s40538-020-00199-z. [Google Scholar] [CrossRef]
13. Sponsel VM. The biosynthesis and metabolism of gibberellins in higher plants. In: Davis PJ, editor. Plant hormones: physiology, biochemistry, and molecular biology. 2nd edDordrecht: Kluwer Academic Pub; 1995. doi:10.1007/978-94-011-0473-9_4. [Google Scholar] [CrossRef]
14. Desta B, Amare G. Paclobutrazol as a plant growth regulator. Chem Biol Technol Agric. 2021;8(1):1. doi:10.1186/s40538-020-00199-z. [Google Scholar] [CrossRef]
15. Paparella S, Araujo SS, Rossi G, Wijayasinghe M, Carbonera D, Balestrazzi A. Seed priming: state of the art and new perspectives. Plant Cell Rep. 2015;34(8):1281–93. doi:10.1007/s00299-015-1784-y. [Google Scholar] [PubMed] [CrossRef]
16. Pratt RG, Janke GD. Pathogenicity of three species of Pythium to seedling and mature plants of grain sorghum. Phytopathology. 1980;70:766–71. [Google Scholar]
17. Leach J, Lang BR, Yoder DC. Methods for selection of mutants and in vivo culture of Cochliobolus heterostrophus. J Gen Microbiol. 1982;128(8):1719–29. doi:10.1099/00221287-128-8-1719. [Google Scholar] [CrossRef]
18. Aurangzeb M, Shafqat A, Bashir I, Gill MA. Physiological studies on Fusarium moniliforme Sheld, the causal organism of bakanae disease of rice. Mycopath. 2003;1(1):49–52. [Google Scholar]
19. Lei C, Sun X. Comparing lethal dose ratios using probit regression with arbitrary slopes. BMC Pharmacol Toxicol. 2018;19(1):61. doi:10.1186/s40360-018-0250-1. [Google Scholar] [PubMed] [CrossRef]
20. Kader MA. A Comparison of seed germination calculation formulae and the associated interpretation of resulting data. J Proc Royal Soc New South Wales. 2005;138:65–75. doi:10.5962/p.361564. [Google Scholar] [CrossRef]
21. Moran R, Porath D. Chlorophyll determination in intact tissues using N, N-Dimethyl formamide. Plant Physiol. 1980;69(3):1370–81. doi:10.1104/pp.65.3.478. [Google Scholar] [PubMed] [CrossRef]
22. Velikova V, Yordanov I, Edreva A. Oxidative stress and some antioxidant systems in acid rain-treated bean plants. Protective role of exogenous polyamines. Plant Sci. 2000;151(1):59–66. doi:10.1016/S0168-9452(99)00197-1. [Google Scholar] [CrossRef]
23. Bates LS, Waldren RP, Teare ID. Rapid determination of free proline for water stress studies. Plant Soil. 1973;39(1):205–7. doi:10.1007/BF00018060. [Google Scholar] [CrossRef]
24. Aebi H. Catalase in vitro. Methods Enzymol. 1984;105:121–6. doi:10.1016/s0076-6879(84)05016-3. [Google Scholar] [PubMed] [CrossRef]
25. Polle A, Otter T, Seifert F. Apoplastic peroxidases and lignification in needles of norway spruce Picea abies L. Plant Physiol. 1994;106(1):53–60. doi:10.1104/pp.106.1.53. [Google Scholar] [PubMed] [CrossRef]
26. Oktay M, Küfrevioğlu I, Kocacalıskan I, Sakiroğlu H. Polyphenol oxidase from amasya apple. J Food Sci. 1995;60(3):495–9. doi:10.1111/j.1365-2621.1995.tb09810.x. [Google Scholar] [CrossRef]
27. Mohd ZNAI, Razak AA, Salleh B. Bakanae disease of rice in Malaysia and Indonesia: etiology of the causal agent based on morphological, physiological and pathogenicity characteristics. J Plant Prot Res. 2008;48(4):475–85. doi:10.2478/v10045-008-0056-z. [Google Scholar] [CrossRef]
28. Duncan DB. Multiple range and multiple F-test. Biometrics. 1955;11(1):1–42. doi:10.2307/3001478. [Google Scholar] [CrossRef]
29. Peng X, Lei C, Sun X. Comparison of lethal doses calculated using logit/probit-log(dose) regressions with arbitrary slopes using R. J Econ Entomol. 2021;114(3):1345–52. doi:10.1093/jee/toab044. [Google Scholar] [PubMed] [CrossRef]
30. Martínez JA, Valdés R, Bañón S. Effects of paclobutrazol on Botrytis cinerea isolates obtained from potted plants. Commun Agric Appl Biol Sci. 2010;75(4):709–19. [Google Scholar]
31. Li M, Li T, Duan Y, Yang Y, Wu J, Zhao D, et al. Evaluation of phenamacril and ipconazole for control of rice bakanae disease caused by Fusarium fujikuroi. Plant Dis. 2018;102(7):1234–9. doi:10.1094/PDIS-10-17-1521-RE. [Google Scholar] [PubMed] [CrossRef]
32. Dewi K, Agustina RZ, Nurmalika F. Effects of blue light and paclobutrazol on seed germination, vegetative growth and yield of black rice (Oryza sativa L. ‘CEMPO IRENG’). Biotropia. 2016;23(2):84–95. doi:10.11598/btb.2016.23.2.478. [Google Scholar] [CrossRef]
33. Pasian CC, Bennett MA. Paclobutrazol soaked marigold, geranium, and tomato seeds produce short seedlings. HortScience. 2001;36(4):721–3. doi:10.21273/HORTSCI.36.4.721. [Google Scholar] [CrossRef]
34. Tesfahun W. A review of the response of crops to Paclobutrazol application. Tesfahun, Cogent Food Agri. 2018;4(1):1525169. doi:10.1080/23311932.2018.1525169. [Google Scholar] [CrossRef]
35. Balano MB, Baňoc DM, Alcober EAL, Teves KLY. Response of lowland rice (Oryza sativa Linn.) var. NSIC Rc216 to the application of paclobutrazol grown in acidic and alkaline soils. SVU-Int J Agri Sci. 2022;4(4):80–95. doi:10.21608/svuijas.2022.181380.1254. [Google Scholar] [CrossRef]
36. Detpitthayanan S, Romyanon K, Songnuan W, Metam M, Pichakum A. Paclobutrazol application improves grain 2AP content of thai jasmine rice KDML105 under low-salinity conditions. J Crop Sci Biotechnol. 2019;22(3):275–82. doi:10.1007/s12892-019-0109-0. [Google Scholar] [CrossRef]
37. Singh V, Kapoor P, Kumar K. Bakanae Disease—a serious threat to basmati rice production in India. J Cereal Res. 2021;14(1):1–12. [Google Scholar]
38. Jaleel CA, Manivannan P, Sankar B, Kishorekumar A, Sankari S, Panneerselvam R. Paclobutrazol enhances photosynthesis and ajmalicine production in Catharanthus roseus. Process Biochem. 2007;42(11):1566–70. doi:10.1016/j.procbio.2007.08.006. [Google Scholar] [CrossRef]
39. Li J, Xu P, Zhang B, Song Y, Wen S, Bai Y, et al. Paclobutrazol promotes root development of difficult-to-root plants by coordinating auxin and abscisic acid signaling pathways in Phoebe bournei. Int J Mol Sci. 2023;24(753):2–18. doi:10.3390/ijms24043753. [Google Scholar] [PubMed] [CrossRef]
40. Basra AS. Plant growth regulators in agriculture and horticulture: Their role and commercial uses. Binghamton: Haworth Press, Inc.; 2000. p. 1–16. [Google Scholar]
41. Miao R, Yuan W, Wang Y, Garcia-Maquilon I, Dang X, Li Y, et al. Low ABA concentration promotes root growth and hydrotropism through relief of ABA INSENSITIVE 1-mediated inhibition of plasma membrane H+-ATPase 2. Sci Adv. 2017;12(12):eabd4113. doi:10.1126/sciadv.abd4113. [Google Scholar] [PubMed] [CrossRef]
42. Khalil IA, Rahman H. Effect of paclobutrazol on growth, chloroplast pigments and sterol biosynthesis of maize (Zea mays L.). Plant Sci. 1995;105(1):15–21. doi:10.1016/0168-9452(94)04028-F. [Google Scholar] [CrossRef]
43. Wang YL, Bai XM, Luo RF, Lu C, Xiang F. Effect of paclobutrazol on the extension and root characteristics of Lolium perenne L. J Desert Res. 2010;30(6):1319–24. [Google Scholar]
44. Liu B, Long S, Liu K, Zhu T, Gong J, Gao S, et al. Paclobutrazol ameliorates low-light-induced damage by improving photosynthesis, antioxidant defense system, and regulating hormone levels in tall fescue. Int J Mol Sci. 2022;23(17):9966. doi:10.3390/ijms23179966. [Google Scholar] [PubMed] [CrossRef]
45. Berova M, Zlatev Z. Physiological response and yield of paclobutrazol treated tomato plants (Lycopersicon esculentum Mill.). Plant Growth Regulat. 2000;30(2):117–23. doi:10.1023/A:1006300326975. [Google Scholar] [CrossRef]
46. Nivedithadevi D, Somasundaram R, Pannerselvam R. Effect of abscisic acid, paclobutrazol and salicylic acid on the growth and pigment variation in Solanum trilobatum (l). Int J Drug Develop Res. 2015;4:236–46. [Google Scholar]
47. An YN, Murugesan C, Choi H, Kim KD, Chun S. Current studies on bakanae disease in rice: host range, molecular identification, and disease management. Mycobiology. 2023;51(4):195–209. doi:10.1080/12298093.2023.2241247. [Google Scholar] [PubMed] [CrossRef]
48. Carnelos D, Lozano-Miglioli J, Giardina E, Tognetti J, di Benedett AH. Cytokinin action revisited: leaf anatomical changes play a key role in 6-benzylaminopurine-driven growth promotion in pot-grown lettuce. Revis Chapingo. Serie Horticul. 2022;28(2):109–32. doi:10.5154/r.rchsh.2021.07.015. [Google Scholar] [CrossRef]
49. Spormann S, Nadais P, Sousa F, Pinto M, Martins M, Sousa B, et al. Accumulation of proline in plants under contaminated soils—are we on the same page? Antioxidants. 2023;12(3):666. doi:10.3390/antiox12030666. [Google Scholar] [PubMed] [CrossRef]
50. Loutfy N, Hassanein A, Inouhe M, Salem J. Biological aspects and proline metabolism genes influenced by polyethylene glycol and salicylic acid in two wheat cultivars. Egypt J Bot. 2022;62(3):671–85. doi:10.21608/ejbo.2022.124280.1921. [Google Scholar] [CrossRef]
51. Panda D, Mishra SS, Behera PK. Drought tolerance in rice: focus on recent mechanisms and approaches. Rice Sci. 2021;28(2):119–32. doi:10.1016/j.rsci.2021.01.002. [Google Scholar] [CrossRef]
52. Frimpong F, Anokye M, Windt CW, Naz AA, Frei M, Dusschoten DV, et al. Proline-mediated drought tolerance in the Barley (Hordeum vulgare L.) isogenic line is associated with lateral root growth at the early seedling stage. Plants. 2021;10(10):2177. doi:10.3390/plants10102177. [Google Scholar] [PubMed] [CrossRef]
53. Shalaby TA, Taha NA, Taher DI, Metwaly MM, El-Beltagi HS, Rezk AA, et al. Paclobutrazol improves the quality of tomato seedlings to be resistant to Alternaria solani blight disease: biochemical and histological perspectives. Plants. 2022;11(3):425. doi:10.3390/plants11030425. [Google Scholar] [PubMed] [CrossRef]
54. Kamran M, Ahmad S, Ahmad I, Hussain I, Meng X, Zhang X, et al. Paclobutrazol application favors yield improvement of maize under semiarid regions by delaying leaf senescence and regulating photosynthetic capacity and antioxidant system during grain-filling stage. Agronomy. 2020;10(2):187. doi:10.3390/agronomy10020187. [Google Scholar] [CrossRef]
55. Amr HA, Abd El Khalek SM. Biochemical and molecular variability of Fusarium fujikuroi isolates and their differential interactions with rice genotypes during infection. Egyptian J Agri Res. 2020;98(1):131–53. doi:10.21608/ejar.2020.114848. [Google Scholar] [CrossRef]
56. El-Beltagi HS, El-Nady MF, Al-Daej MI, El-Naqma KA, Rezk AA, El-Afry MM, et al. Exogenous application of manganese and arginine alleviates the adverse effects of salinity stress on pea (Pisum sativum L.). Cogent Food Agri. 2024;10(1):2389445. doi:10.1080/23311932.2024.2389445. [Google Scholar] [CrossRef]
57. Fathurrahman F, Zahrah S, Heriyanto E, Mahadi I. The effects of the growth regulator paclobutrazol on physiological characteristics of rain tree (Albizia saman Jacq. Merr.). J Ecol Eng. 2023;24(12):346–55. doi:10.12911/22998993/173396. [Google Scholar] [CrossRef]
58. Zhang S. Recent advances of polyphenol oxidases in plants. Molecules. 2023;28(5):2158. doi:10.3390/molecules28052158. [Google Scholar] [PubMed] [CrossRef]
59. Kostopoulou P, Karatassıou M. Photosynthetic response of Bromus inermis in grasslands of different altitudes. Turk J Agric For. 2016;40(4):642–53. doi:10.3906/tar-1602-50. [Google Scholar] [CrossRef]
60. Xing X, Tang Y, Wei M, Zhao D. Effect of paclobutrazol application on plant photosynthetic performance and leaf greenness of Herbaceousp peony. Horticulturae. 2018;4(1):5. doi:10.3390/horticulturae4010005. [Google Scholar] [CrossRef]
61. Xie Q, Essemine J, Pang X, Chen H, Jin J, Cai W. Abscisic acid regulates the root growth trajectory by reducing auxin transporter PIN2 protein levels in Arabidopsis thaliana. Front Plant Sci. 2021;12:632676. doi:10.3389/fpls.2021.632676. [Google Scholar] [PubMed] [CrossRef]
62. Du C, Shen F, Li Y, Zhao Z, Xu X, Jiang J, et al. Effects of salicylic acid, jasmonic acid and reactive oxygen species on the resistance of Solanum peruvianum to Meloidogyne incognita. Sci Hortic. 2021;275(3):109649. doi:10.1016/j.scienta.2020.109649. [Google Scholar] [CrossRef]
63. Gorshkov AP, Kusakin PG, Borisov YG, Tsyganova AV, Tsyganov VE. Effect of triazole fungicides titul duo and vintage on the development of pea (Pisum sativum L.) symbiotic nodules. Int J Mol Sci. 2023;24(10):8646. doi:10.3390/ijms24108646. [Google Scholar] [PubMed] [CrossRef]
64. Wu W, Wan X, Shah F, Fahad S, Huang J. The role of antioxidant enzymes in adaptive responses to sheath blight infestation under different fertilization rates and hill densities. The Sci World J. 2014;2014(2):502134. doi:10.1155/2014/502134. [Google Scholar] [PubMed] [CrossRef]
65. Soylu EM, Soylu S, Baysal Ö. Induction of disease resistance and antioxidant enzymes by acibenzolar-S-methyl against bacterial canker (Clavibacter michiganensis subsp. michiganensis) in tomato. J Plant Pathol. 2003;165(5):1069–75. doi:10.1016/S0168-9452(03)00302-9. [Google Scholar] [CrossRef]
Cite This Article
Copyright © 2024 The Author(s). Published by Tech Science Press.This work is licensed under a Creative Commons Attribution 4.0 International License , which permits unrestricted use, distribution, and reproduction in any medium, provided the original work is properly cited.


Submit a Paper
Propose a Special lssue
View Full Text
Download PDF
Downloads
Citation Tools